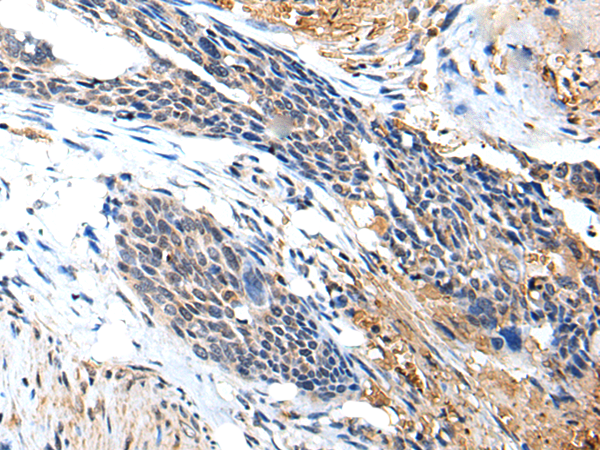
一抗

英文名稱: Anti-PTPRG rabbit polyclonal antibody
別 名: PTPG; HPTPG; RPTPG; R-PTP-GAMMA
相關(guān)類別: 一抗
儲 存: 冷凍(-20℃)
宿 主: Rabbit
抗 原: PTPRG
反應(yīng)種屬: Human, Mouse
標(biāo)記物: Unconjugate
克隆類型: rabbit polyclonal
技術(shù)規(guī)格
Background:
The protein encoded by this gene is a member of the protein tyrosine phosphatase (PTP) family. PTPs are known to be signaling molecules that regulate a variety of cellular processes including cell growth, differentiation, mitotic cycle, and oncogenic transformation. This PTP possesses an extracellular region, a single transmembrane region, and two tandem intracytoplasmic catalytic domains, and thus represents a receptor-type PTP. The extracellular region of this PTP contains a carbonic anhydrase-like (CAH) domain, which is also found in the extracellular region of PTPRBETA/ZETA. This gene is located in a chromosomal region that is frequently deleted in renal cell carcinoma and lung carcinoma, thus is thought to be a candidate tumor suppressor gene.
Applications:
ELISA, IHC
Name of antibody:
PTPRG
Immunogen:
Synthetic peptide of human PTPRG
Full name:
protein tyrosine phosphatase receptor type G
Synonyms:
PTPG; HPTPG; RPTPG; R-PTP-GAMMA
SwissProt:
P23470
ELISA Recommended dilution:
5000-10000
IHC positive control:
Human colorectal cancer
IHC Recommend dilution:
50-200

 購物車
購物車 幫助
幫助
 021-54845833/15800441009
021-54845833/15800441009